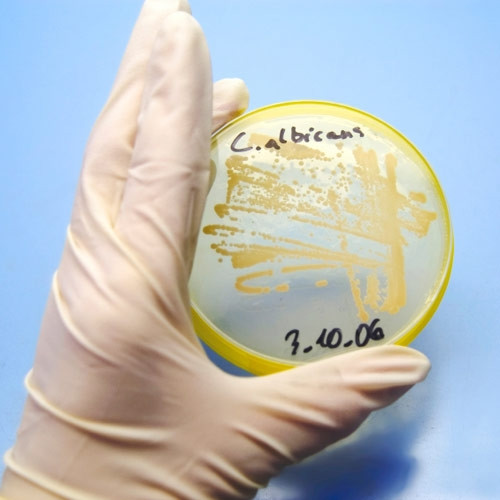
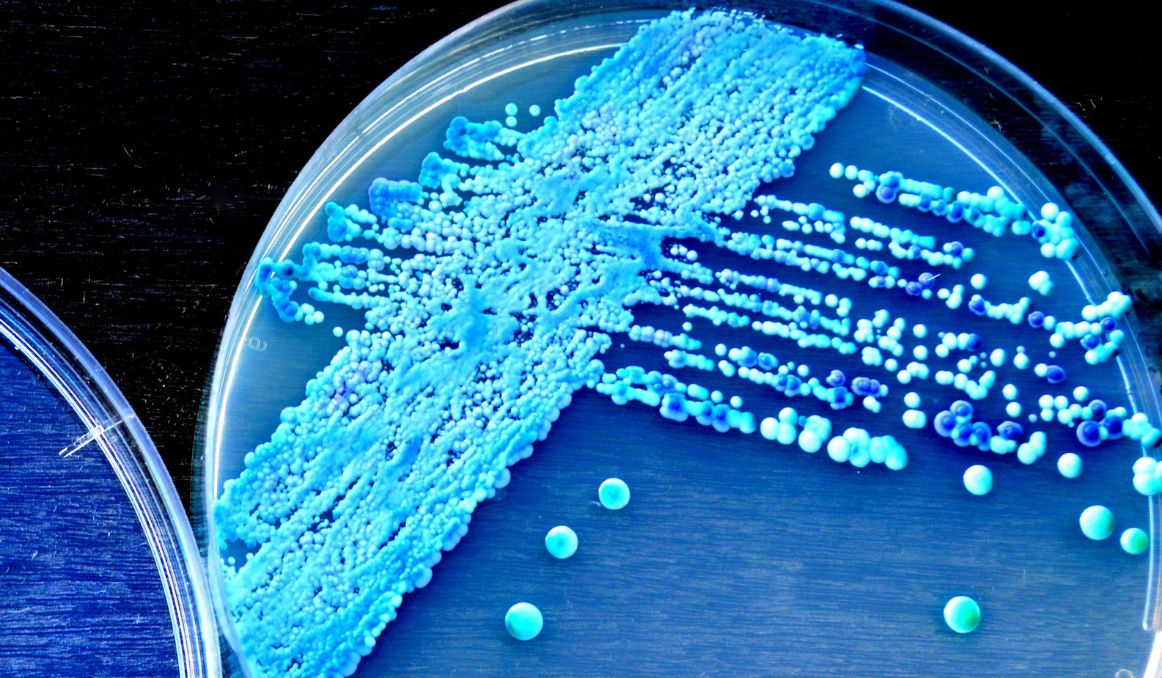

How To Stop A Yeast Infection Before It Gets Bad
Milfs And Machines
Japan Game Show Porn
Ssbbw Squash
Lesbianporn Stars
Hentai Femdom Foot
Tanya Roberts Porn
Milf Brunette Hd
Hiddendana squirts face multiple times pic
Blond webcam show
Your Free Porno Tv
SwankMag Video: Shalina Devine and James Brossman
Youngest stretched pussy
Bare Bubble Butt Teens
How To Stop A Yeast Infection Before It Gets Bad 118 photos